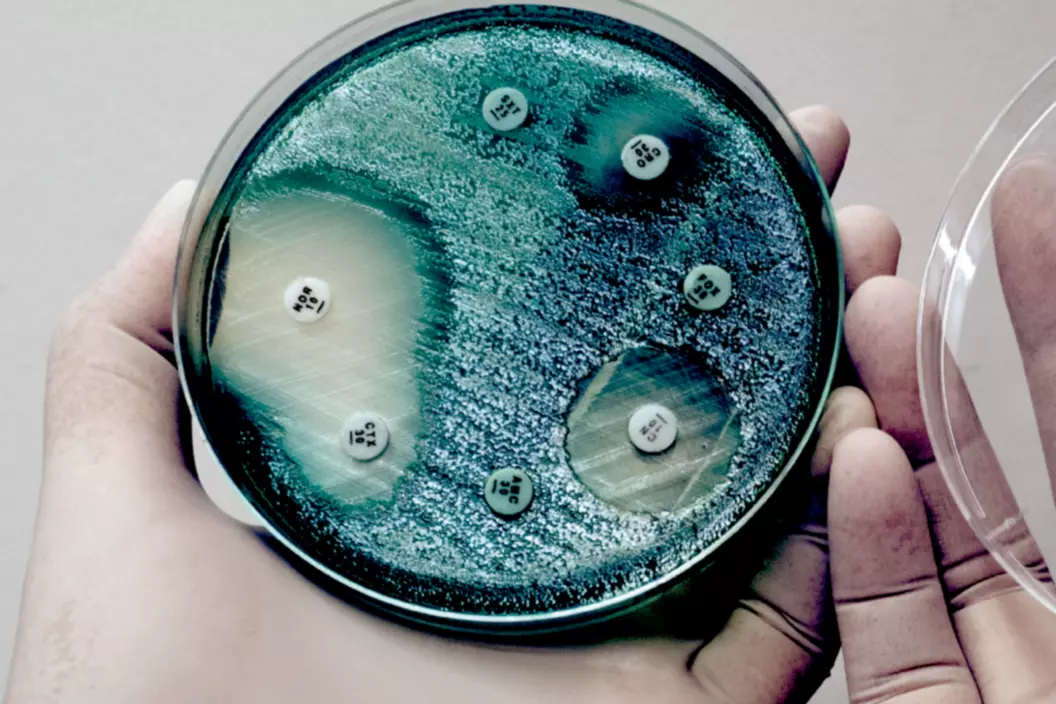

Publié par Martinez Elena
Salle de colloque IHM, av. de Provence 82, Lausanne
Historicising the "Empty Pipeline" | How Antibiotic Innovation Became A Market Failure
Conférence de Claas Kirchhelle, historien et professeur associé au CERMES3/INSERM à Paris, dans le cadre des « Drug History Lectures » et du projet FNS Pediatric Drugs.
Organisation et modération : Felix Rietmann, IHM, CHUV-UNIL
Voir tous les événements